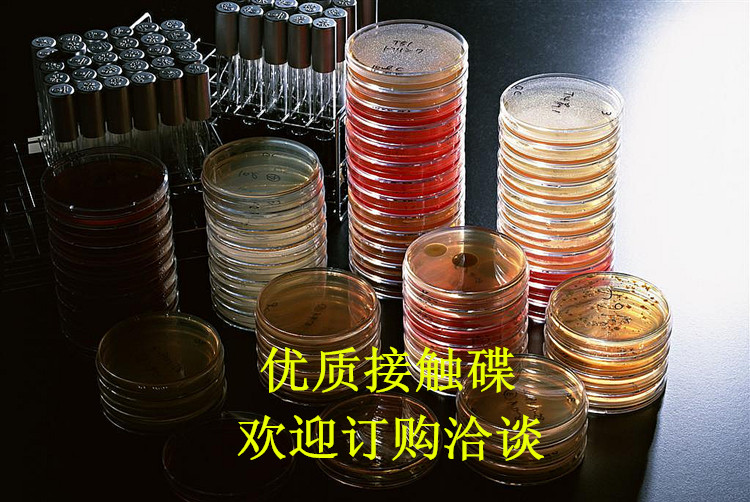
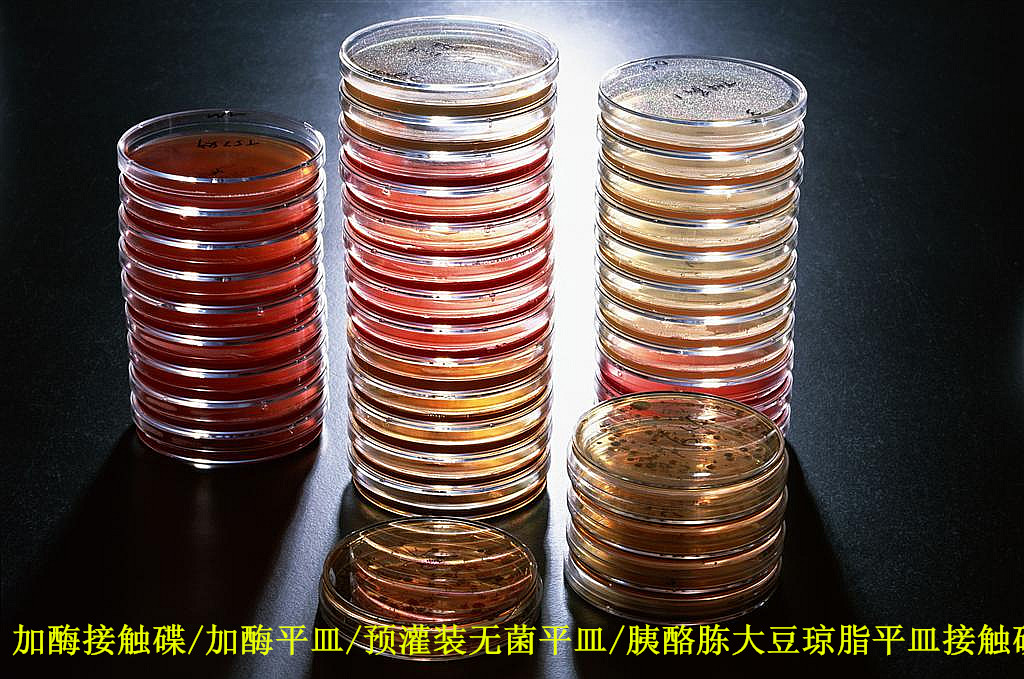

厂家低直销 重复使用 接触碟55mm 表面接触皿 微生物取样

用于设备、车间、人员、包装材料等表面微生物的测定。取代棉签擦拭法,减少取样步骤,确保取样的准确性和安全性。培养基有效表面积为25cm2,符合新版GMP标准所规定的取样要求。
特点:1.湿热灭菌,可以重复使用。
2.透光率好,摔不烂。(材质:俗称金属玻璃)
3.密闭性好,培养5-7天,培养基不会干裂。
4.内径55mm,培养基有效表面积为25cm2 ,符合新版GMP表面微生物取样的要求。
*您的姓名:
*联系手机:
固话电话:
E-mail:
所在单位:
需求数量:
*咨询内容: